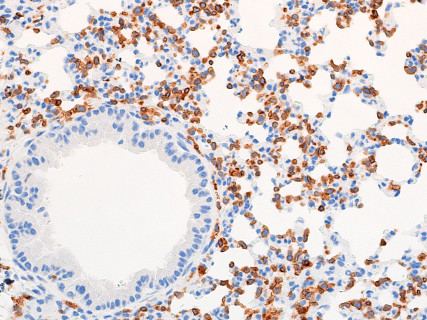

The pathological analysis of abnormal findings in laboratory animals is indispensable in determining the cause of diseases. Especially in the definite diagnosis of infectious diseases, detection of the pathogen in the tissue is important as well as microbial testing. In addition to infections, pathological diagnosis of spontaneous tumors, inflammation, and xenogenetic cells (e.g., human cells) is also performed. H&E staining, special staining and immunohistochemistry using automatic stainer (Bond-Max) are available.
【Activities】
Preparation of pathological specimens


Staining



Pathological diagnosis

PAGE TOP